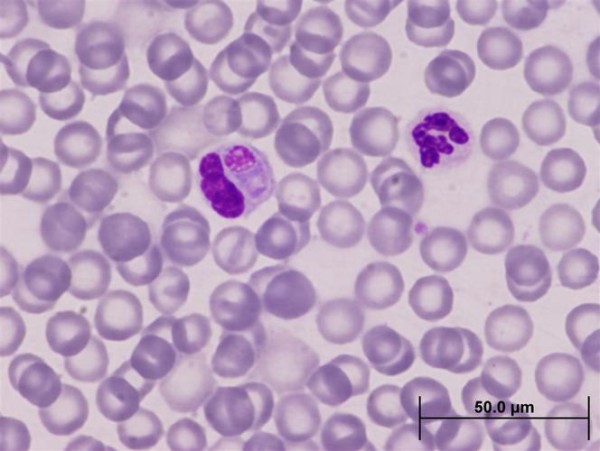

韩国艺人近距离接触大熊猫引发健康风险担忧
发布时间:2025-11-09 09:51
01艺人接触大熊猫
近日,有传闻称在一档韩国综艺节目中,几位韩国艺人竟然与仅3个月大的大熊猫宝宝“福宝”进行了近距离的接触。节目中,这些艺人带着妆容,不仅拥抱了熊猫宝宝,还触碰了它,甚至有人被揭露家中饲养有宠物。此举引发了中国网友的强烈不满,他们担忧这些行为可能会让大熊猫受到疾病的威胁。

> 近距离接触可能的风险
据成都大熊猫繁育研究基地的工作人员介绍,人类身上的细菌和病毒对大熊猫确实构成威胁,因此,不仅不能随意触摸大熊猫,一般的游客甚至都无法进入熊猫繁育基地的内部。此外,网友们所提及的“犬瘟热”是一种对大熊猫致死率极高的传染病。该病毒主要感染犬科及猫科动物,通过直接接触病兽或空气、食物等途径传播,传染性极高,死亡率可达90%。虽然人类不会感染此病毒,但接触过病兽后也可能成为病毒的携带者。
> 熊猫保护原则的建议
对于大熊猫这样的保护动物,我们应该遵循“可远观而不可亵玩焉”的原则。它们虽然可爱,但并非家庭宠物,对它们的最好爱护就是保持距离,避免打扰它们的生活。
举报/反馈
网址:韩国艺人近距离接触大熊猫引发健康风险担忧 https://mxgxt.com/news/view/1845049
相关内容
韩女团违规接触大熊猫,带妆与熊猫宝宝近距离接触韩国艺人在综艺中亲密接触熊猫引发争议
韩国女团带妆近距离接触大熊猫引争议 当事大熊猫“福宝”刚满百日
韩国综艺中违规接触大熊猫的风波与保护措施
韩国综艺中艺人大熊猫接触引发广泛关注与讨论
韩国艺人违规接触熊猫幼崽引热议 BLACKPINK违规接触熊猫事件详情
韩国艺人违规接触熊猫幼崽引争议,被国内网民骂惨了
韩国艺人违规接触熊猫幼崽惹怒网友,大熊猫到底能不能摸?
blackpink违规接触熊猫宝宝,带妆近距离接触,还有成员养宠物狗
韩国艺人违规接触熊猫幼崽

